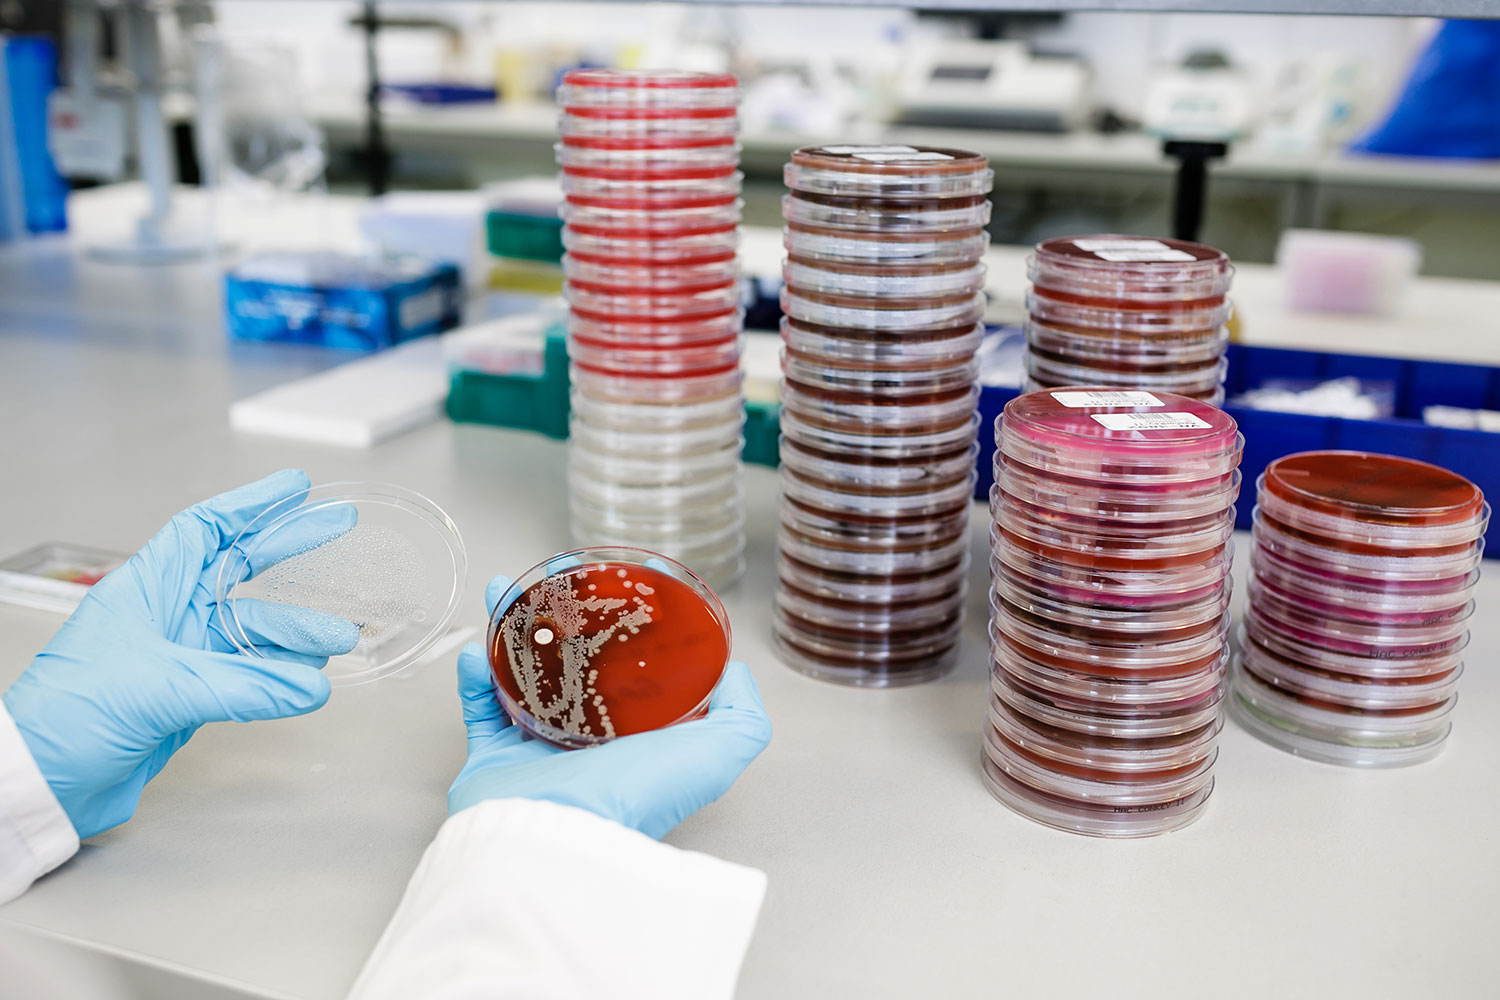

Mehr als nur ein Labor
Kompetenz für spezielle Labordiagnostik
Wir sind ein hochspezialisiertes komplementärmedizinisches Labor. Bei uns geht es um mehr als die Messung von Laborwerten. Mit unserer Kompetenz und Expertise sind wir der Laborpartner des Therapeuten auch bei der Diagnose komplexer, chronischer Erkrankungen. Modernste Technologien und innovative Analytik schaffen die Voraussetzung für eine differenzierte Befundinterpretation. Wir beraten individuell, integrativ und präventionsorientiert.

Leistungsverzeichnis
Your content goes here. Edit or remove this text inline or in the module Content settings.

Unsere Therapeuten
Your content goes here. Edit or remove this text inline or in the module Content settings.

Flexible Kachel
Your content goes here. Edit or remove this text inline or in the module Content settings.

Für Patienten
Your content goes here. Edit or remove this text inline or in the module Content settings.

Mediathek
Your content goes here. Edit or remove this text inline or in the module Content settings.
International
Your content goes here. Edit or remove this text inline or in the module Content settings.
Aktuelles
Neuer Beitrag
Lorem ipsum dolor sit amet, consectetuer adipiscing elit. Aenean commodo ligula eget dolor. Aenean massa. Cum sociis natoque penatibus et magnis dis parturient montes, nascetur ridiculus mus. Donec quam felis,...
Neuer Beitrag
Lorem ipsum dolor sit amet, consectetuer adipiscing elit. Aenean commodo ligula eget dolor. Aenean massa. Cum sociis natoque penatibus et magnis dis parturient montes, nascetur ridiculus mus. Donec quam felis,...
Neuer Beitrag
Lorem ipsum dolor sit amet, consectetuer adipiscing elit. Aenean commodo ligula eget dolor. Aenean massa. Cum sociis natoque penatibus et magnis dis parturient montes, nascetur ridiculus mus. Donec quam felis,...



